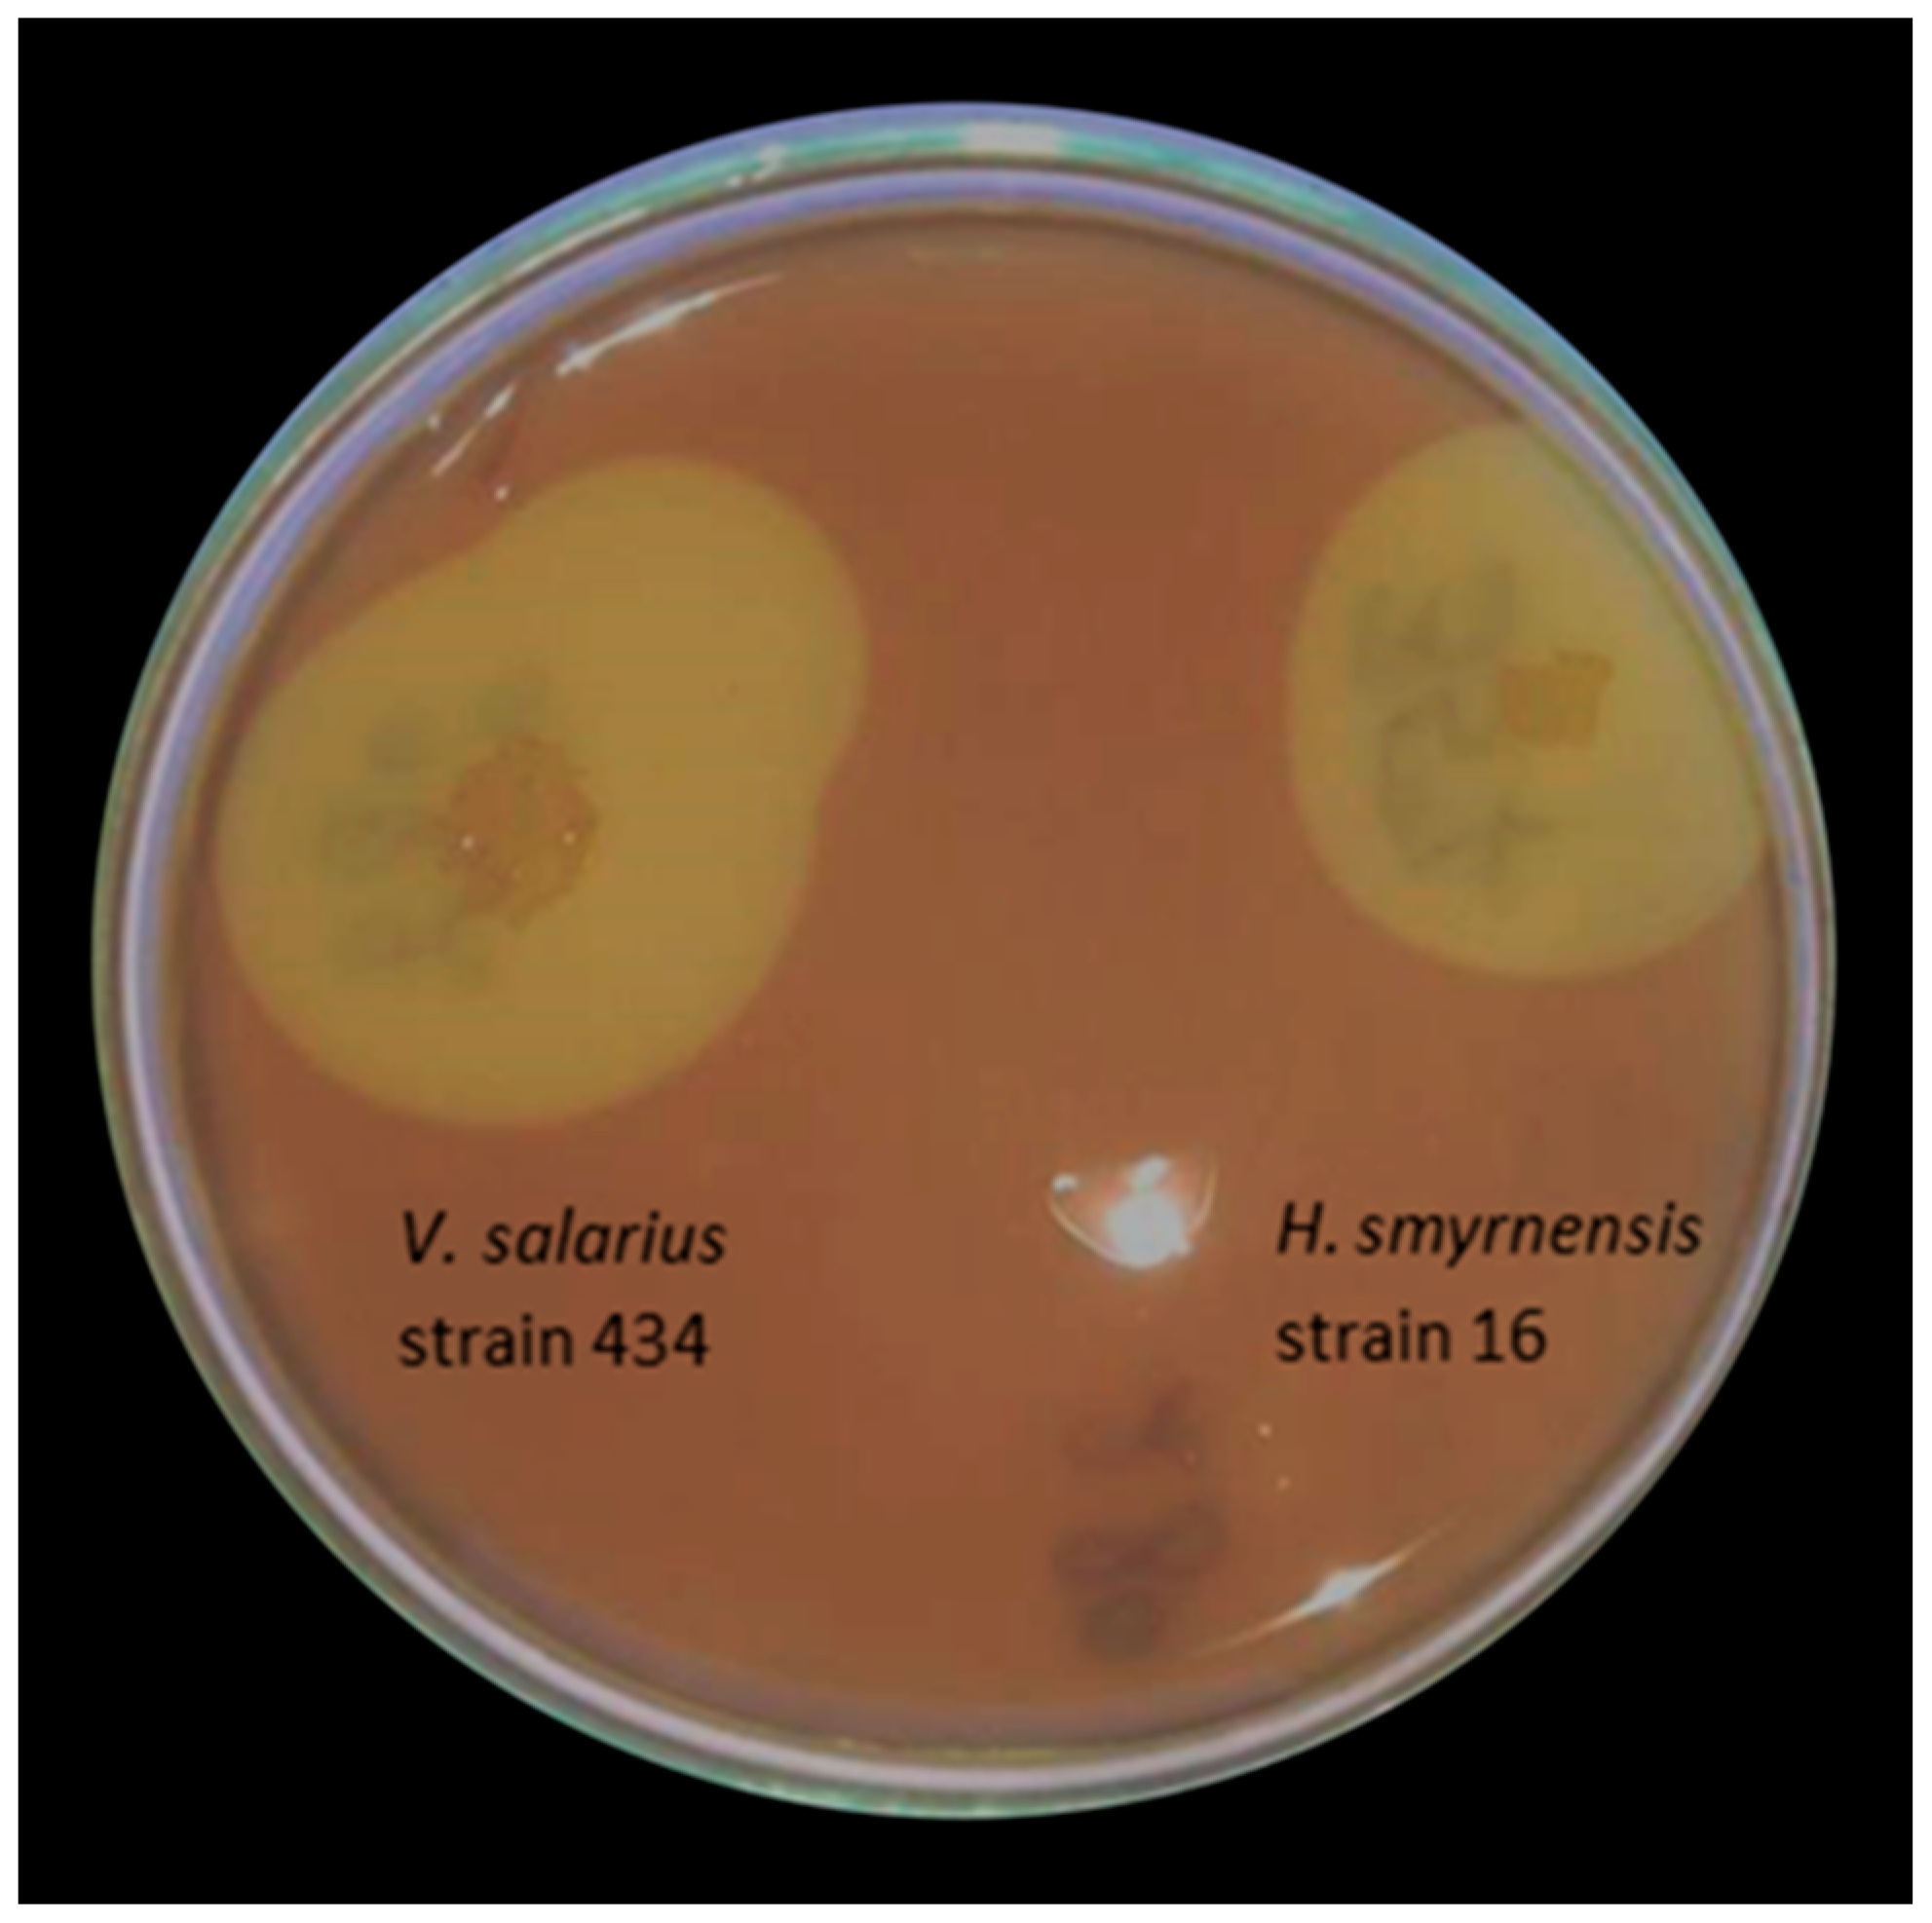
Applsci 14 09295 g001 Applsci 14 09295 g001

Extracellular Haloalkalophilic Pectinase Produced by Virgibacillus salarius Strain 434—A Useful Tool for Biotechnological Applications
Abstract
Featured Application
Abstract
1. Introduction
2. Materials and Methods
2.1. Reagents and Chemicals
2.2. Bacterial Strains
2.3. Medium Optimization
2.4. Enzyme Activity and Protein Quantitation
2.5. Partial Purification and Molecular Weight Determination of the Pectinase from V. salarius Strain 434
2.6. Optimization of Different Reaction Parameters for the Maximum Pectinase Activity
2.7. Effects of Metal Ions, Inhibitors, and Surfactants on Bacterial Pectinase
2.8. Kinetic Parameters Determination
2.9. Statistical Analysis
3. Results
3.1. Strain Producers
3.2. Optimization of Pectinase Production by V. salarius Strain 434
3.3. Partial Purification and Molecular Weight Determination of the Pectinase Synthesized by V. salarius Strain 434
3.4. Optimization of Reaction Parameters for Maximum Pectinase Activity
3.5. Effects of Metal Ions, Inhibitors, and Surfactants on the Bacterial Pectinase
3.6. Kinetic Parameters
4. Conclusions
Author Contributions
Funding
Institutional Review Board Statement
Informed Consent Statement
Data Availability Statement
Conflicts of Interest
References
- Alqahtani, Y.S.; More, S.S.; Keerthana, R.; Shaikh, I.A.; Anusha, K.J.; More, V.; Niyonzima, F.; Muddapur, U.; Khan, A. Production and Purification of Pectinase from Bacillus Subtilis 15A-B92 and Its Biotechnological Applications. Molecules 2022, 27, 4195. [Google Scholar] [CrossRef] [PubMed]
- Murugan, T.; Deepika, P.; Kowsalya, A.; Sivasubramanian, K.; Rejisha, R.P.; Murugan, M.; Albino Wins, J. Production and Characterization of Extracellular Pectinase from a Newly Isolated Bacillus Species from Fruit Waste Soil. Mater. Today Proc. 2021, 45, 2087–2090. [Google Scholar] [CrossRef]
- Carrasco, M.; Rozas, J.M.; Alcaíno, J.; Cifuentes, V.; Baeza, M. Pectinase secreted by psychrotolerant fungi: Identification, molecular characterization and heterologous expression of a cold-active polygalacturonase from Tetracladium sp. Microb. Cell Factories 2019, 7, 45. [Google Scholar] [CrossRef]
- Jayani, R.S.; Saxena, S.; Gupta, R. Microbial Pectinolytic Enzymes: A Review. Process Biochem. 2005, 40, 2931–2944. [Google Scholar] [CrossRef]
- Hoondal, G.S.; Tiwari, R.P.; Tewari, R.; Dahiya, N.; Beg, Q.K. Microbial Alkaline Pectinases and Their Industrial Applications: A Review. Appl. Microbiol. Biotechnol. 2002, 59, 409–418. [Google Scholar] [CrossRef]
- Liu, X.; Kokare, C. Microbial Enzymes of Use in Industry. In Biotechnology of Microbial Enzymes; Academic Press: Cambridge, MA, USA, 2023; pp. 405–444. ISBN 978-0-443-19059-9. [Google Scholar]
- Mevarech, M.; Frolow, F.; Gloss, L.M. Halophilic enzymes: Proteins with a grain of salt. Biophys. Chem. 2000, 86, 155–164. [Google Scholar] [CrossRef]
- Gupta, M.; Choudhury, B.; Navani, N.K. Production and characterization of an organic solvent activated protease from haloalkaliphilic bacterium Halobiforma sp. strain BNMIITR. Heliyon 2024, 10, e25084. [Google Scholar] [CrossRef] [PubMed]
- Chaudhari, H.G.; Wardah, Z.H.; Prajapati, V.; Raol, G. Halozymes: Sources, catalytic mechanisms, and potential applications in industries. In Extremozymes and Their Industrial Applications; Academic Press: Cambridge, MA, USA, 2022; pp. 279–287. [Google Scholar] [CrossRef]
- Gurung, N.; Ray, S.; Bose, S.; Rai, V. A broader view: Microbial enzymes and their relevance in industries, medicine, and beyond. BioMed Res. Int. 2013, 329121. [Google Scholar] [CrossRef]
- Hmidet, N.; Ali, N.E.H.; Haddar, A.; Kanoun, S.; Alya, S.K.; Nasri, M. Alkaline proteases and thermostable α-amylase co-produced by Bacillus licheniformis NH1: Characterization and potential application as detergent additive. Biochem. Eng. J. 2009, 47, 71–79. [Google Scholar] [CrossRef]
- Rathakrishnan, D.; Gopalan, A.K. Isolation and Characterization of Halophilic Isolates from Indian Salterns and Their Screening for Production of Hydrolytic Enzymes. Environ. Chall. 2022, 6, 100426. [Google Scholar] [CrossRef]
- Flores-Fernández, C.N.; Cárdenas-Fernández, M.; Lye, G.J.; Ward, J.M. Synergistic action of thermophilic pectinases for pectin bioconversion into D-galacturonic acid. Enzym. Microb. Technol. 2022, 160, 110071. [Google Scholar] [CrossRef] [PubMed]
- Dhiman, S.S.; Mahajan, R.; Sharma, J. Pectinases of Thermophilic Microbes. In Thermophilic Microbes in Environmental and Industrial Biotechnology: Biotechnology of Thermophiles; Springer: Berlin/Heidelberg, Germany, 2013; pp. 689–710. [Google Scholar] [CrossRef]
- Sani, R.K.; Krishnaraj, R.N. Extremophilic Enzymatic Processing of Lignocellulosic Feedstocks to Bioenergy; Springer: Cham, Switzerland, 2017; ISBN 978-3-319-54683-4. [Google Scholar]
- Rosenberg, E.; DeLong, E.F.; Lory, S.; Stackebrandt, E.; Thompson, F. The Prokaryotes: Firmicutes and Tenericutes; No. 15426; Springer: Berlin/Heidelberg, Germany, 2014. [Google Scholar] [CrossRef]
- Yousef, N.M.; Mawad, A.M. Characterization of thermo/halo stable cellulase produced from halophilic Virgibacillus salarius BM-02 using non-pretreated biomass. World J. Microbiol. Biotechnol. 2023, 39, 22. [Google Scholar] [CrossRef] [PubMed]
- Gomaa, M.; Yousef, N. Optimization of production and intrinsic viscosity of an exopolysaccharide from a high yielding Virgibacillus salarius BM02: Study of its potential antioxidant, emulsifying properties and application in the mixotrophic cultivation of Spirulina platensis. Int. J. Biol. Macromol. 2020, 149, 552–561. [Google Scholar] [CrossRef] [PubMed]
- Elazzazy, A.M.; Abdelmoneim, T.S.; Almaghrabi, O.A. Isolation and characterization of biosurfactant production under extreme environmental conditions by alkali-halo-thermophilic bacteria from Saudi Arabia. Saudi J. Biol. Sci. 2015, 22, 466–475. [Google Scholar] [CrossRef] [PubMed]
- Boyadzhieva, I.; Tomova, I.; Radchenkova, N.; Kambourova, M.; Poli, A.; Vasileva-Tonkova, E. Diversity of Heterotrophic Halophilic Bacteria Isolated from Coastal Solar Salterns, Bulgaria and Their Ability to Synthesize Bioactive Molecules with Biotechnological Impact. Microbiology 2018, 87, 519–528. [Google Scholar] [CrossRef]
- Collmer, A.; Ried, J.L.; Mount, M.S. Assay Methods for Pectic Enzymes. In Methods in Enzymology; Academic Press Inc.: Cambridge, MA, USA, 1988; Volume 161, pp. 329–335. ISBN 978-0-12-182062-6. [Google Scholar]
- Hagerman, A.E.; Austin, P.J. Continuous Spectrophotometric Assay for Plant Pectin Methyl Esterase. J. Agric. Food Chem. 1986, 34, 440–444. [Google Scholar] [CrossRef]
- Miller, G.L. Use of DinitrosaIicyIic Acid Reagent for Determination of Reducing Sugar. Anal. Chem. 1959, 31, 426–428. [Google Scholar] [CrossRef]
- Lowry, O.H.; Rosebrough, N.J.; Farr, A.L.; Randall, R.J. Protein Measurement with the Folin Phenol Reagent. J. Biol. Chem. 1951, 193, 265–275. [Google Scholar] [CrossRef]
- Laemmli, U.K. Cleavage of Structural Proteins during the Assembly of the Head of Bacteriophage T4. Nature 1970, 227, 680–685. [Google Scholar] [CrossRef]
- Whitaker, J.R. Determination of Molecular Weights of Proteins by Gel Filtration on Sephadex. Anal. Chem. 1963, 35, 1950–1953. [Google Scholar] [CrossRef]
- Oumer, O.J.; Abate, D. Characterization of Pectinase from Bacillus Subtilis Strain Btk 27 and Its Potential Application in Removal of Mucilage from Coffee Beans. Enzym. Res. 2017, 2017, 686904. [Google Scholar] [CrossRef] [PubMed]
- Boyadzhieva, I.; Radchenkova, N.; Atanasova, N.; Poli, A.; Finore, I.; Kambourova, M. Isolation and Characterization of a Thermostable Pectinase by Anoxybacillus gonensis Strain 357. Comptes Rendus L’acade’Mie Bulg. Sci. 2021, 74, 1757–1766. [Google Scholar] [CrossRef]
- Zhang, G.; Li, S.; Xu, Y.; Wang, J.; Wang, F.; Xin, Y.; Shen, Z.; Zhang, H.; Ma, M.; Liu, H. Production of alkaline pectinase: A case study investigating the use of tobacco stalk with the newly isolated strain Bacillus tequilensis CAS-MEI-2-33. BMC Biotechnol. 2019, 19, 45. [Google Scholar] [CrossRef] [PubMed]
- Cherekar, M.N.; Pathak, A.P. Production and Characterization of a Haloalkaline Pectinase from Halomonas pantellerinsis Strain SSL8 Isolated from Sambhar Lake, Rajasthan. Curr. Trends Biotechnol. Pharm. 2020, 14, 319–326. [Google Scholar] [CrossRef]
- Karray, F.; Ben Abdallah, M.; Kallel, N.; Hamza, M.; Fakhfakh, M.; Sayadi, S. Extracellular hydrolytic enzymes produced by halophilic bacteria and archaea isolated from hypersaline lake. Mol. Biol. Rep. 2018, 45, 1297–1309. [Google Scholar] [CrossRef]
- Prakash, S.; Karthik, R.; Tamil Venthan, M.; Sridhar, B.; Bharath, P. Optimization and Production of Pectinase from Bacillus Subtilis (MTCC 441) by Using Orange peel as A Substrate. Int. J. Recent Sci. Res. 2014, 5, 1177–1179. [Google Scholar]
- Kaur, S.; Kaur, H.P.; Prasad, B.; Bharti, T. Production and Optimization of Pectinase by Bacillus sp. Isolated from Vegetable Waste Soil. Indo Am. J. Pharm. Res. 2016, 6, 4185–4190. [Google Scholar]
- Jayani, R.S.; Shukla, S.K.; Gupta, R. Screening of Bacterial Strains for Polygalacturonase Activity: Its Production by Bacillus Sphaericus (MTCC 7542). Enzym. Res. 2010, 2010, 306785. [Google Scholar] [CrossRef]
- Mukesh Kumar, D.J.; Saranya, G.M.; Suresh, K.; Andal, P.; Rajakumar, R.; Kalaichelvan, P. Production and Optimization of Pectinase from Bacillus sp. MFW7 Using Cassava Waste. Asian J. Plant Sci. Res. 2012, 2, 369–375. [Google Scholar]
- Rastegari, B.; Karbalaei-Heidari, H.R. Isolation and Partial Characterization of a Bacterial Thermostable Polymethyl Galacturonase from a Newly Isolated Bacillus sp. Strain BR1390. Iran J. Biotechnol. 2014, 12, 41–46. [Google Scholar] [CrossRef][Green Version]
- Ashour Sanaa, M.A.; Zeinab, M.H.K.; Eldiwany, A.I.; Maany, D.A. Production, Purification and Characterization of Polysaccharide Lytic Enzymes of a Marine Isolate, Bacillus Cereus NRC-20 and Their Application in Biofilm Removal. Afr. J. Microbiol. Res. 2014, 8, 2492–2504. [Google Scholar] [CrossRef]
- Bhardwaj, V.; Garg, N. Production, Purification of Pectinase from Bacillus sp. MBRL576 Isolate and Its Application in Extraction of Juice. Int. J. Sci. Res. 2014, 3, 648–652. [Google Scholar]
- Takao, M.; Nakaniwa, T.; Yoshikawa, K.; Terashita, T.; Sakai, T. Purification and Characterisation of Thermostable Pectate Lyase with Protopectinase Activity from Thermophilic Bacillus sp. TS 47. Biosci. Biotechnol. Biochem. 2000, 64, 2360–2367. [Google Scholar] [CrossRef]
- Andrade, M.V.V.D.; Delatorre, A.B.; Ladeira, S.A.; Martins, M.L.L. Production and Partial Characterization of Alkaline Polygalacturonase Secreted by Thermophilic Bacillus sp. SMIA-2 under Submerged Culture Using Pectin and Corn Steep Liquor. Ciênc. Tecnol. Aliment. 2011, 31, 204–208. [Google Scholar] [CrossRef]
- Roy, K.; Dey, S.; Uddin, M.K.; Barua, R.; Hossain, M.T. Extracellular pectinase from a novel bacterium Chryseobacterium indologenes strain SD and its application in fruit juice clarification. Enzym. Res. 2018, 2018, 3859752. [Google Scholar] [CrossRef]
- Krajewska, B. Mono-(Ag, Hg) and di-(Cu, Hg) valent metal ions effects on the activity of jack bean urease. Probing the modes of metal binding to the enzyme. J. Enzym. Inhib. Med. Chem. 2008, 23, 535–542. [Google Scholar] [CrossRef] [PubMed]
- Yue, L.-M.; Lee, J.; Lü, Z.-R.; Yang, J.-M.; Ye, Z.-M.; Park, Y.-D. Effect of Cd2+ on tyrosinase: Integration of inhibition kinetics with computational simulation. Int. J. Biol. Macromol. 2017, 94, 836–844. [Google Scholar] [CrossRef]
- Karoui-Kharrat, D.; Kaddour, H.; Hamdi, Y.; Mokni, M.; Amri, M.; Mezghani, S. Response of antioxidant enzymes to cadmium-induced cytotoxicity in rat cerebellar granule neurons. Open Life Sci. 2017, 12, 113–119. [Google Scholar] [CrossRef]
- Kusuma, M.P.; Reddy, D.S.R. Purification and Characterisation of Polygalacturonase Using Isolated Bacillus subtilis C4. Res. J. Microbiol. 2014, 9, 95–103. [Google Scholar] [CrossRef]
- Li, G.; Xue, Y.; Zhou, C.; Zhang, Y.; Ma, Y. Cloning, Expression, and Characterization of a Highly Active Alkaline Pectate Lyase from Alkaliphilic Bacillus sp. N16-5. J. Microbiol. Biotechnol. 2010, 20, 670–677. [Google Scholar] [CrossRef]
- Li, S.; Yang, X.; Yang, S.; Zhu, M.; Wang, X. Technology prospecting on enzymes: Application, marketing and engineering. Comput. Struct. Biotechnol. J. 2012, 2, e201209017. [Google Scholar] [CrossRef]
- Amid, M.; Manap, Y.; Zohdi, K. Purification and Characterisation of Thermo-Alkaline Pectinase Enzyme from Hylocereus polyrhizus. Eur. Food Res. Technol. 2014, 239, 21–29. [Google Scholar] [CrossRef]
- Zohdi, N.; Amid, M. Optimization of Extraction of Novel Pectinase Enzyme Discovered in Red Pitaya (Hylocereus polyrhizus) Peel. Molecules 2013, 18, 14366–14380. [Google Scholar] [CrossRef] [PubMed]
- Rahman, S.; Choi, Y.S.; Kim, Y.K.; Park, C.; Yoo, J.C. Production of Novel Polygalacturonase from Bacillus paralicheniformis CBS32 and Application to Depolymerization of Ramie Fiber. Polymers 2019, 11, 1525. [Google Scholar] [CrossRef]

| Species | Isolate Number | Pectinase Activity, U/mg |
|---|---|---|
| Halomonas smyrnensis | 16 | 4.5 ± 0.04 |
| 17 | 3.3 ± 0.03 | |
| 18 | 2.0 ± 0.03 | |
| 19 | 2.3 ± 0.02 | |
| 26 | 1.9 ± 0.02 | |
| Halomonas variabilis | 13 | 0.4 ± 0.03 |
| 15 | 0.5 ± 0.04 | |
| 438 | 0.2 ± 0.01 | |
| Halomonas eurihalina | 20 | 0.7 ± 0.02 |
| 27 | 0.5 ± 0.02 | |
| U1 | 0.0 | |
| Halomonas halophila | U2 | 1.8 ± 0.02 |
| Cobetia marina | 437 | 0.3 ± 0.01 |
| 439 | 0.5 ± 0.03 | |
| Chromohalobacter canadensis | 21 | 1.5 ± 0.03 |
| 28 | 1.8 ± 0.04 | |
| Salinivibrio costicola | 22 | 2.5 ± 0.02 |
| 23 | 2.0 ± 0.02 | |
| Nesiotobacter exalbescens | 24 | 1.3 ± 0.02 |
| Brevibacterium casei | 11 | 1.8 ± 0.04 |
| Virgibacillus salarius | 434 | 7.5 ± 0.03 |
| Salinicoccus roseus | MK-V | 0.0 |
| Purification Step | Total Activity (U) | Total Protein (mg) | Specific Activity (U/mg) | Purification Fold | Purification Yield % |
|---|---|---|---|---|---|
| Crude enzyme | 1825 ± 0.04 | 200 ± 0.03 | 9.1 ± 0.02 | 1 | 100 |
| Ultrafiltration | 1015 ± 0.02 | 65 ± 0.01 | 15.6 ± 0.02 | 1.7 | 56 |
| Gel filtration | 521.5 ± 0.01 | 5 ± 0.01 | 104.3 ± 0.01 | 11.5 | 29 |
| Substrate, (1%) | Enzyme Activity (U/mg) | Relative Activity (%) |
|---|---|---|
| Polygalacturonic acid | 132 | 100 ± 1.7 |
| Citrus pectin | 102 | 77 ± 1.0 |
| Apple pectin | 99 | 75 ± 1.3 |
| Xylan | 19.8 | 15 ± 1.0 |
| Galactose | 10 | 7.5 ± 1.5 |
Disclaimer/Publisher’s Note: The statements, opinions and data contained in all publications are solely those of the individual author(s) and contributor(s) and not of MDPI and/or the editor(s). MDPI and/or the editor(s) disclaim responsibility for any injury to people or property resulting from any ideas, methods, instructions or products referred to in the content. |
© 2024 by the authors. Licensee MDPI, Basel, Switzerland. This article is an open access article distributed under the terms and conditions of the Creative Commons Attribution (CC BY) license (https://creativecommons.org/licenses/by/4.0/).
Share and Cite
Boyadzhieva, I.; Berberov, K.; Atanasova, N.; Krumov, N.; Kabaivanova, L. Extracellular Haloalkalophilic Pectinase Produced by Virgibacillus salarius Strain 434—A Useful Tool for Biotechnological Applications. Appl. Sci. 2024, 14, 9295. https://doi.org/10.3390/app14209295
Boyadzhieva I, Berberov K, Atanasova N, Krumov N, Kabaivanova L. Extracellular Haloalkalophilic Pectinase Produced by Virgibacillus salarius Strain 434—A Useful Tool for Biotechnological Applications. Applied Sciences. 2024; 14(20):9295. https://doi.org/10.3390/app14209295
Chicago/Turabian StyleBoyadzhieva, Ivanka, Kaloyan Berberov, Nikolina Atanasova, Nikolay Krumov, and Lyudmila Kabaivanova. 2024. "Extracellular Haloalkalophilic Pectinase Produced by Virgibacillus salarius Strain 434—A Useful Tool for Biotechnological Applications" Applied Sciences 14, no. 20: 9295. https://doi.org/10.3390/app14209295
APA StyleBoyadzhieva, I., Berberov, K., Atanasova, N., Krumov, N., & Kabaivanova, L. (2024). Extracellular Haloalkalophilic Pectinase Produced by Virgibacillus salarius Strain 434—A Useful Tool for Biotechnological Applications. Applied Sciences, 14(20), 9295. https://doi.org/10.3390/app14209295

